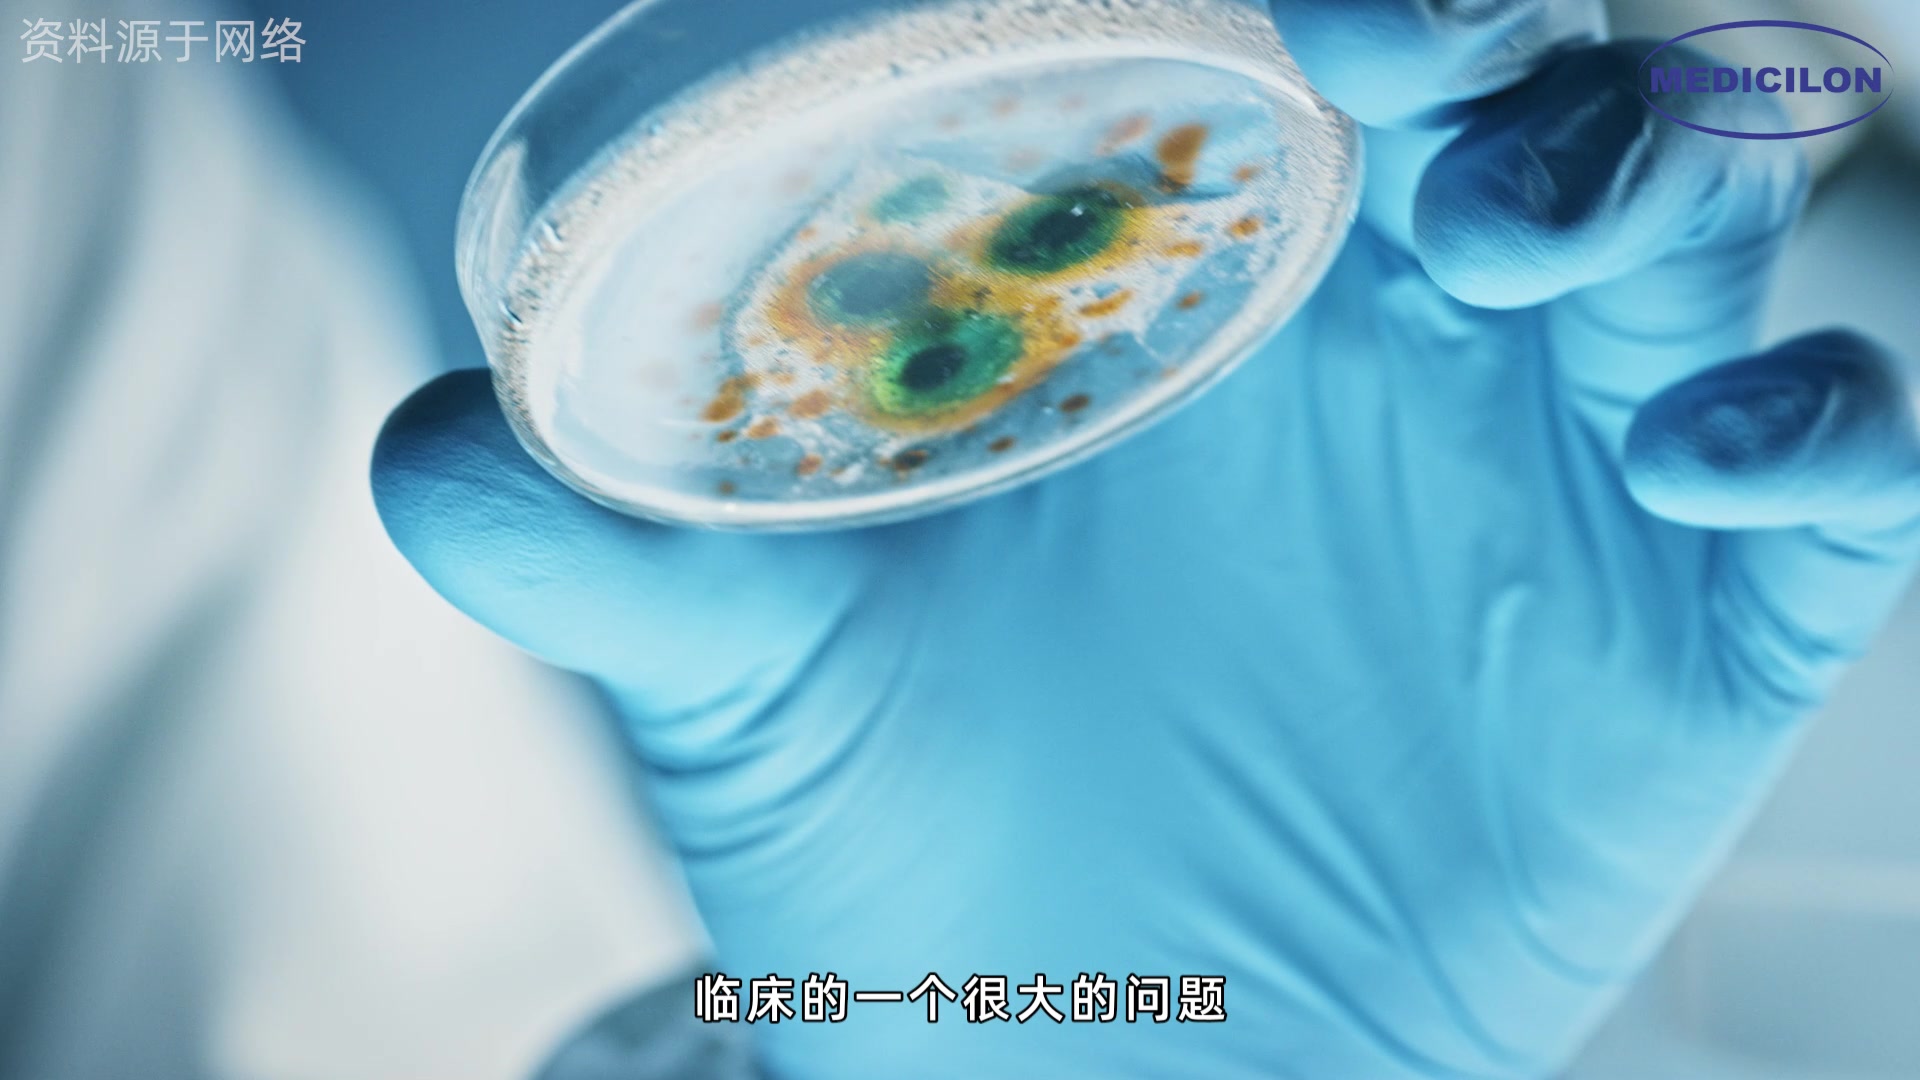
医药会客厅-对话姜远英院长|共探抗真菌药物研发新突

耐美迪卫浴

耐美迪卫浴加盟费
图片尺寸600x400
耐美迪卫浴加盟费
图片尺寸600x400
2【付尾款啦!】加购清单!
图片尺寸800x800
丨柜子收纳丨在马桶后方装一个壁柜做收纳,将日常所需的卫浴用品分类
图片尺寸640x426
朴智旻#
图片尺寸690x5449
光力科技_债 德龙激光 凯盛科技 凯盛新能 金龙机电 凯格精机 美迪凯
图片尺寸1280x1702
地产大政策
图片尺寸800x1510
耐美迪4d超漩式马桶_卫浴_中联水工网
图片尺寸427x407
美迪奇卫浴新闻动态_意大利美迪奇卫浴(中国)有限公司企业动态-中华
图片尺寸640x853
朴智旻#
图片尺寸690x4357
朴智旻#
图片尺寸690x690
(图片来源:美迪奇卫浴官网,侵删)
图片尺寸700x900
5月20日可转债早参考
图片尺寸650x800
卫生间老是湿漉漉,小心对家人健康不利--美迪装饰
图片尺寸728x485
卫生间老是湿漉漉,小心对家人健康不利--美迪装饰
图片尺寸728x1090
美迪奇卫浴新闻动态_意大利美迪奇卫浴(中国)有限公司企业动态-中华
图片尺寸632x752
医药会客厅-对话姜远英院长|共探抗真菌药物研发新突
图片尺寸1920x1080
卫生间装修,选对三大件,卫生间也可以很舒适!
图片尺寸640x480
朴智旻#
图片尺寸690x690
朴智旻#
图片尺寸690x690